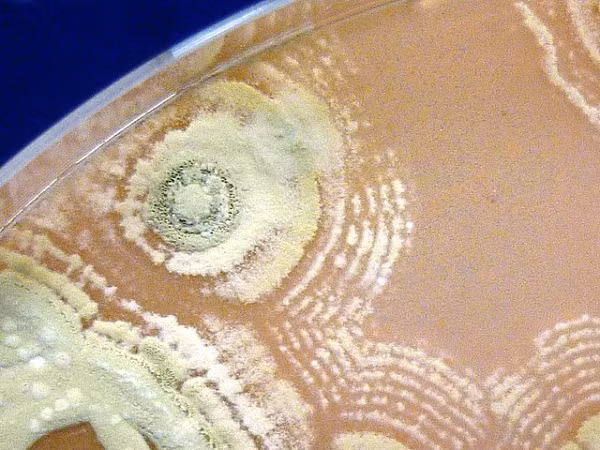
Đó là một loạt nấm và vi khuẩn bao gồm Actinobacteria (vi khuẩn giúp phân hủy vật liệu thực vật) và Firmicutes (giúp tăng trưởng thực vật, kiểm soát mầm bệnh) và nấm men chịu nhiệt Basidioacus hay Penicillium.
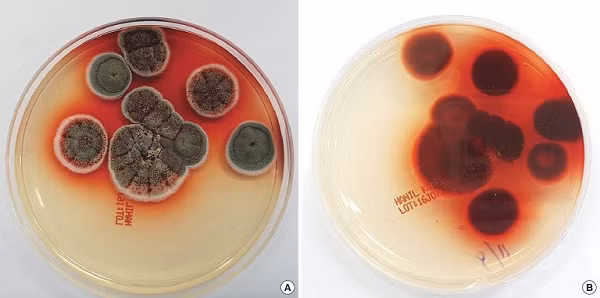
Một số loại vi khuẩn bất ngờ phát huy mạnh mẽ khả năng biến đổi carbon và ni-tơ trong đất sau đám cháy.
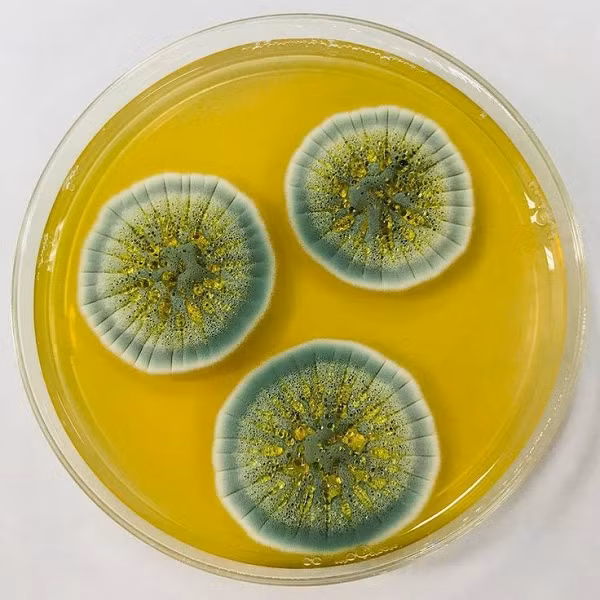
Phát hiện này có ý nghĩa vô cùng to lớn đối với các nhà khoa học. Loại nấm sống được trong môi trường "hoả ngục" sẽ giúp họ tìm ra hướng đi mới trong việc tái thiết thảm xanh sau thiên tai.

![[GALLERY] RF Online Next gây sốc, huyền thoại 20 năm hồi sinh ngoạn mục](https://cdn.kienthuc.net.vn/images/190e30c7c04ee6e7103089027c41b3a9fe59cba704dba9818dc512afa7f442bcffe4cc997d19e3f0e6b9d93b56842403/rf-5.png.avif)
![[GALLERY] Điện thoại không rơi vẫn nứt kính, thủ phạm gây sốc ít ai ngờ](https://cdn.kienthuc.net.vn/images/190e30c7c04ee6e7103089027c41b3a9a69b10b6e27efb7624afeedd980a7bf12ecd2cc4ccacbeb970a1fc67c6faba48/nut-4.png.avif)
![[GALLERY] BYD Atto 2 chạy 45km "không uống 1 giọt xăng", rộng cửa về Việt Nam](https://cdn.kienthuc.net.vn/images/9296f0377c64048406d89ea0c83995cbaa2f09cb5010a93da44658e5ded0d5cc47561cd0d0282bd855364161751495c1/8-3711.jpg.avif)
![[GALLERY] Hyundai Elantra 2027 ra mắt - thiết kế lớn hơn, công nghệ vượt trội](https://cdn.kienthuc.net.vn/images/9296f0377c64048406d89ea0c83995cbaa2f09cb5010a93da44658e5ded0d5cc1567fca24fc91e05eab85aa0ed4de221/1-9144.jpg.avif)
![[GALLERY] Hongqi E-HS9 2026 ra mắt Thái Lan - SUV hạng sang điện giá 2,5 tỷ](https://cdn.kienthuc.net.vn/images/9296f0377c64048406d89ea0c83995cbaa2f09cb5010a93da44658e5ded0d5cc7f1035b1d98b81c88af09f5d017fd039/3-575.jpg.avif)

![[GALLERY] Ngắm Morgan Midsummer Coupe giới hạn 9 chiếc, thiết kế siêu đẹp](https://cdn.kienthuc.net.vn/images/9296f0377c64048406d89ea0c83995cbaa2f09cb5010a93da44658e5ded0d5cc5c0402480f243e39d46a906be37404d6/11.jpg.avif)
![[GALLERY] 432 robot Trung Quốc nhấc bổng khu phố cổ 7.500 tấn gây sốc](https://cdn.kienthuc.net.vn/images/190e30c7c04ee6e7103089027c41b3a9196551afad761e33b85c651f8fe65afd954da3ff2f0fea89cd20191999440356/cong-7.png.avif)
![[GALLERY] BYD Atto 2 chạy 45km "không uống 1 giọt xăng", rộng cửa về Việt Nam](https://cdn.kienthuc.net.vn/images/74db2820f1946736a44f941aef7fe4afaa2f09cb5010a93da44658e5ded0d5cc47561cd0d0282bd855364161751495c1/8-3711.jpg.avif)
Mẫu xe SUV cỡ nhỏ BYD Atto 2 2026 phiên bản hybrid sạc điện DM-i đã bất ngờ được đưa đến Philippines để trưng bày như dấu hiệu cho việc xe sắp được bán ra.

![[GALLERY] Hyundai Elantra 2027 ra mắt - thiết kế lớn hơn, công nghệ vượt trội](https://cdn.kienthuc.net.vn/images/fa6fa22794e1049e63e79fd6d1d3f051aa2f09cb5010a93da44658e5ded0d5cc1567fca24fc91e05eab85aa0ed4de221/1-9144.jpg.avif)

![[GALLERY] Hongqi E-HS9 2026 ra mắt Thái Lan - SUV hạng sang điện giá 2,5 tỷ](https://cdn.kienthuc.net.vn/images/fa6fa22794e1049e63e79fd6d1d3f051aa2f09cb5010a93da44658e5ded0d5cc7f1035b1d98b81c88af09f5d017fd039/3-575.jpg.avif)
![[GALLERY] RF Online Next gây sốc, huyền thoại 20 năm hồi sinh ngoạn mục](https://cdn.kienthuc.net.vn/images/fc6b1457645b26575fcbba0a62d9d7d4fe59cba704dba9818dc512afa7f442bcffe4cc997d19e3f0e6b9d93b56842403/rf-5.png.avif)
Sau hơn 20 năm ngủ quên, RF Online chính thức trở lại với RF Online Next, sở hữu đồ họa Unreal Engine 5 và chiến trường quy mô lớn gây sốt.
![[GALLERY] Điện thoại không rơi vẫn nứt kính, thủ phạm gây sốc ít ai ngờ](https://cdn.kienthuc.net.vn/images/fc6b1457645b26575fcbba0a62d9d7d4a69b10b6e27efb7624afeedd980a7bf12ecd2cc4ccacbeb970a1fc67c6faba48/nut-4.png.avif)
Nhiều người thắc mắc vì sao điện thoại không hề rơi nhưng kính cường lực vẫn nứt vỡ. Nguyên nhân lại đến từ một thói quen rất phổ biến hàng ngày.
![[GALLERY] BYD Atto 2 chạy 45km "không uống 1 giọt xăng", rộng cửa về Việt Nam](https://cdn.kienthuc.net.vn/images/fa6fa22794e1049e63e79fd6d1d3f051aa2f09cb5010a93da44658e5ded0d5cc47561cd0d0282bd855364161751495c1/8-3711.jpg.avif)
Mẫu xe SUV cỡ nhỏ BYD Atto 2 2026 phiên bản hybrid sạc điện DM-i đã bất ngờ được đưa đến Philippines để trưng bày như dấu hiệu cho việc xe sắp được bán ra.
![[GALLERY] Hyundai Elantra 2027 ra mắt - thiết kế lớn hơn, công nghệ vượt trội](https://cdn.kienthuc.net.vn/images/fa6fa22794e1049e63e79fd6d1d3f051aa2f09cb5010a93da44658e5ded0d5cc1567fca24fc91e05eab85aa0ed4de221/1-9144.jpg.avif)
Hyundai vừa ra mắt thế hệ mới của mẫu sedan Hyundai Avante 2027 tại Hàn Quốc. Tại một số thị trường trong đó có Việt Nam, xe có tên là Hyundai Elantra.
![[GALLERY] Hongqi E-HS9 2026 ra mắt Thái Lan - SUV hạng sang điện giá 2,5 tỷ](https://cdn.kienthuc.net.vn/images/fa6fa22794e1049e63e79fd6d1d3f051aa2f09cb5010a93da44658e5ded0d5cc7f1035b1d98b81c88af09f5d017fd039/3-575.jpg.avif)
Mẫu SUV điện hạng sang Hongqi E-HS9 vừa chính thức ra mắt tại thị trường Thái Lan, sau Singapore. Đây là phiên bản tay lái nghịch dành cho Đông Nam Á.

Dự án cầu Trần Hưng Đạo đang được thi công khẩn trương giữa sông Hồng, khu vực nội thành cũng được nhà thầu đưa lượng lớn máy móc đến công trường...
![[GALLERY] Ngắm Morgan Midsummer Coupe giới hạn 9 chiếc, thiết kế siêu đẹp](https://cdn.kienthuc.net.vn/images/fa6fa22794e1049e63e79fd6d1d3f051aa2f09cb5010a93da44658e5ded0d5cc5c0402480f243e39d46a906be37404d6/11.jpg.avif)
Phiên bản mui trần Midsummer đã bán hết, vì vậy Morgan và Pininfarina đã thiết kế lại nó thành một chiếc grand tourer kín với mui kính và thép ấn tượng.
![[GALLERY] 432 robot Trung Quốc nhấc bổng khu phố cổ 7.500 tấn gây sốc](https://cdn.kienthuc.net.vn/images/fc6b1457645b26575fcbba0a62d9d7d4196551afad761e33b85c651f8fe65afd954da3ff2f0fea89cd20191999440356/cong-7.png.avif)
Trung Quốc gây kinh ngạc khi sử dụng 432 robot cỡ nhỏ để di dời khu phố cổ nặng 7.500 tấn tại Thượng Hải nhằm xây dựng tổ hợp hạ tầng ngầm hiện đại.

Xem tử vi hàng ngày, tử vi 12 con giáp hôm nay cho thấy tuổi Tuất làm chủ mọi việc, ký kết được nhiều hợp đồng có giá trị lớn giúp tài chính sung túc.
![[GALLERY] Geely EX5 2027 nâng cấp - tăng sức mạnh, thêm dẫn động cầu sau](https://cdn.kienthuc.net.vn/images/fa6fa22794e1049e63e79fd6d1d3f051aa2f09cb5010a93da44658e5ded0d5ccd0ee44684bfae64e3457ee0a941d40f5/3.jpg.avif)
Dù ngoại hình chỉ nâng cấp nhẹ, Geely EX5 2027 tại Trung Quốc lại có những cải tiến về vận hành khi chuyển sang cấu hình dẫn động cầu sau và tăng công suất.
![[GALLERY] Voidling Bound gây sốt Steam với 94% đánh giá tích cực](https://cdn.kienthuc.net.vn/images/fc6b1457645b26575fcbba0a62d9d7d4b3bc5e9ac6acc611ac88f34b1f4bb276de3534b74792b6570c817dfee7a0e0b2/tua-1.png.avif)
Tựa game khoa học viễn tưởng lấy cảm hứng từ Pokémon đang tạo cơn sốt trên Steam khi đạt 94% đánh giá tích cực chỉ sau vài ngày ra mắt.
![[GALLERY] Phát hiện 5 tính năng Samsung cực hay nhưng ít người biết](https://cdn.kienthuc.net.vn/images/fc6b1457645b26575fcbba0a62d9d7d43b2dc12f21a483a5862a35e302002ab7e2c2de614f65b9e5d63e139eec9e3cab/bat-1.png.avif)
Nhiều người dùng Galaxy lâu năm cũng bất ngờ khi phát hiện loạt tính năng hữu ích được Samsung tích hợp sẵn nhưng gần như không quảng bá rộng rãi.
![[GALLERY] Chi tiết Kia Carnival Hybrid Luxury tại Việt Nam, chỉ 1,399 tỷ đồng](https://cdn.kienthuc.net.vn/images/fa6fa22794e1049e63e79fd6d1d3f051aa2f09cb5010a93da44658e5ded0d5cce7d137c44743eb53258ed77a34ca1213/3-5531.jpg.avif)
Mẫu xe Kia Carnival Hybrid Luxury với giá mềm hơn mang tới một lựa chọn dễ tiếp cận, cùng mức tiêu hao nhiên liệu thấp hơn hẳn so với động cơ đốt trong.
![[GALLERY] Tận thấy Toyota Century SUV - xe công vụ của Thủ tướng Nhật Bản](https://cdn.kienthuc.net.vn/images/fa6fa22794e1049e63e79fd6d1d3f051aa2f09cb5010a93da44658e5ded0d5cc0c590994fea4fcb0e99b3b7a57485674/1-528.jpg.avif)
Mẫu xe SUV Toyota Century SUV đã chính thức được lựa chọn làm phương tiện công vụ mới của Thủ tướng Nhật Bản Sanae Takaichi, thay thế cho dòng Century sedan.
![[GALLERY] Suzuki Swift Sport "hồi sinh" với gói phụ kiện chỉ 39 triệu đồng](https://cdn.kienthuc.net.vn/images/fa6fa22794e1049e63e79fd6d1d3f051aa2f09cb5010a93da44658e5ded0d5cc2a4472e28dfface44af9601aee43e254/3-7493.jpg.avif)
Diện mạo của Suzuki Swift sắc sảo hơn nhờ thay đổi với gói phụ kiện Sport, nó không động đến khung gầm và hệ truyền động của mẫu hatchback cỡ nhỏ này.

Xem tử vi hàng ngày, tử vi 12 con giáp hôm nay cho thấy tuổi Mùi có thể đạt được thành tựu trong sự nghiệp và gặp may mắn khi đầu tư, tiền bạc về đầy túi.
![[GALLERY] Tỷ phú đổ tỷ USD săn bất tử, cái giá khiến nhiều người sốc](https://cdn.kienthuc.net.vn/images/fc6b1457645b26575fcbba0a62d9d7d4cf048880028638b5a5a90c4a05bc07c8263cf29fc547d4d638a5ab3f5d83a633/tham-3.png.avif)
Nhiều tỷ phú công nghệ đang tự biến mình thành "chuột bạch" để kéo dài tuổi thọ, bất chấp cảnh báo y tế về những rủi ro nghiêm trọng đến sức khỏe.
![[GALLERY] Skoda Kodiaq RS "cháy hàng" tại Ấn Độ, bán 50 chiếc trong 6 phút](https://cdn.kienthuc.net.vn/images/fa6fa22794e1049e63e79fd6d1d3f051aa2f09cb5010a93da44658e5ded0d5cc183a28692e9739ff1ca61375b79cec68/1-3248.jpg.avif)
Lô xe đầu tiên của Skoda Kodiaq RS tại thị trường Ấn Độ đã nhanh chóng “cháy hàng” chỉ sau 6 phút mở bán. Đây là mẫu SUV nhanh nhất mà Skoda từng phân phối.
![[GALLERY] Xuất hiện smartphone tích hợp máy chiếu kèm siêu pin](https://cdn.kienthuc.net.vn/images/8366023e10990871ea1458fbe73c9bf1bc19083411254a879434fb582f2c74c2b30798764e905ccec4301ff6d32d991fb0d123015c4e9f522761673fb2f99ebf53afcde00b44db82d75b520dbebf1cd636532c9325c064ca1854858eba391e202b6b1ecf54f8f6d11fa4481d59f7e0a8023233db6fd30b96f97e1b61d0f395ab/avatar1781941746452-17819417468631511611501-0-0-750-1200-crop-17819419115741937167952.jpg.avif)
Có một hãng smartphone chỉ chuyên làm ra các sản phẩm siêu bền, siêu pin từ những chiếc smartphone cho đến cả máy tính bảng đều tích hợp máy chiếu.
![[GALLERY] Toyota Land Cruiser HEV gần 3 tỷ tại Philippines, sắp về Việt Nam](https://cdn.kienthuc.net.vn/images/fa6fa22794e1049e63e79fd6d1d3f051aa2f09cb5010a93da44658e5ded0d5ccb87d1f33b06b479f25de844bf2361198/1.jpg.avif)
Toyota Motor Philippines vừa chính thức mở bán mẫu Land Cruiser HEV. Phiên bản hybrid của Land Cruiser có mức giá 6,93 triệu peso Philippines (gần 3 tỷ đồng).